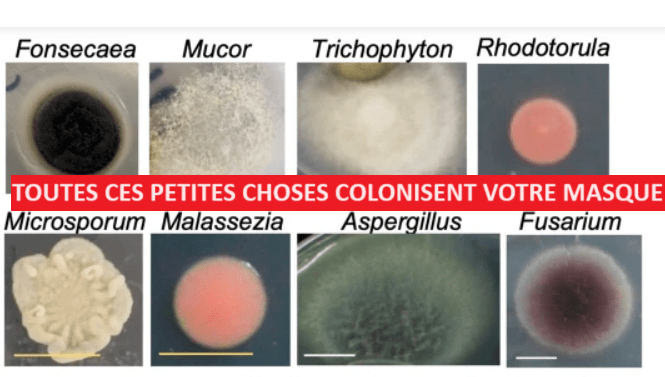

Cette revue d’études scientifiques donne le frisson , on découvre combien les bactéries et les champignons adorent TOUS les masques . Allez savoir pourquoi la protection contre les virus et en particulier la covid
1 Un masquage constant conduit à une exposition directe aux bactéries et aux champignons constamment inhalés.
Ceci est particulièrement alarmant puisque Aspergillus, Cryptococcus, Pneumocystis et les champignons endémiques sont d’importants agents pathogènes fongiques pulmonaires qui entraînent des maladies et la mort.
Nous avons observé des colonies bactériennes dans 99 % des échantillons du côté face et 94 % du côté externe ;
Nous avons observé des colonies fongiques dans 79 % des échantillons sur la face avant et 95 % sur la face externe.
Nous avons détecté B. cereus , un pathogène d’origine alimentaire, sur la face externe des masques chez 5 % des participants , ce qui suggère que B. cereus pourrait adhérer aux masques par les mains à partir des excréments.
Staphylococcus saprophyticus est une des principales causes d’infections urinaires
Fonsecaea pedrosoi est l’un des principaux agents responsables de la chromoblastomycose humaine , une infection fongique chronique localisée sur la peau et les tissus sous-cutanés .
Certaines espèces d’Aspergillus peuvent être pathogènes pour l’Homme (Aspergillus fumigatus), les animaux et les plantes. Les mycoses provoqués par Aspergillus sont appelées des aspergilloses.
Pneumocystis jirovecii est une cause fréquente de pneumonie chez les patients immunodéprimés, en particulier chez les patients infectés par le VIH et ceux qui reçoivent un traitement par corticostéroïdes. Les symptômes comprennent une fièvre, une dyspnée et une toux sèche.
Même si nous avions prévu que le nombre de colonies bactériennes pourrait augmenter en raison de la durée d’utilisation du masque, cela n’a pas été le cas. Le besoin en humidité des bactéries peut expliquer cela
les champignons ont tendance à s’accumuler et à augmenter avec une utilisation prolongée du masque. Lorsque nous avons comparé le nombre de colonies microbiennes entre les types de masques, il n’y avait pas de différences substantielles dans le nombre de colonies microbiennes entre les types de masques non tissés et les autres types de masques.
Nous avions pour objectif (1) de quantifier et d’identifier les bactéries et les champignons se fixant aux masques, et (2) d’étudier si les microbes fixés sur les masques pouvaient être associés aux types et à l’utilisation des masques et aux modes de vie individuels. Nous avons interrogé 109 volontaires sur leur utilisation des masques et leur mode de vie, et avons cultivé des bactéries et des champignons sur le côté facial ou extérieur de leurs masques. Le nombre de colonies bactériennes était plus élevé du côté de la face que du côté extérieur ; le nombre de colonies fongiques était moindre du côté de la face que du côté extérieur. Une utilisation plus longue du masque a considérablement augmenté le nombre de colonies fongiques, mais pas le nombre de colonies bactériennes. Bien que la plupart des microbes identifiés soient non pathogènes chez l’homme ; Staphylococcus epidermidis , Staphylococcus aureus , et Cladosporium , nous avons trouvé plusieurs microbes pathogènes ; Bacillus cereus, Staphylococcus saprophyticus , Aspergillus et Microsporum . Nous n’avons également trouvé aucune association entre les microbes attachés au masque et les méthodes de transport ou les gargarismes. Nous proposons que les personnes immunodéprimées évitent l’utilisation répétée de masques pour prévenir les infections microbiennes.
Types de masques faciaux et tailles de microbes. ( a ) Images macroscopiques et microscopiques de trois types différents de masques faciaux disponibles dans le commerce. Les masques non tissés comportent trois couches : la taille des pores des couches externe et interne est identique (50 à 150 µm) ; la taille des pores de la couche intermédiaire (considérée comme un filtre) est plus petite (5 à 30 µm). Les images microscopiques ont été prises par le microscope Olympus CX33 avec la caméra CCD DP22 (barre = 500 µm). ( b ) Taille des pores, épaisseur, couche et utilisation prévue de trois types de masques. La taille des pores des masques faciaux selon les instructions du fabricant a été confirmée à l’aide des images microscopiques présentées en ( a ) (panneaux de droite). ( c ) La taille standard des microbes et des particules (panneau de gauche) et leurs comparaisons avec la taille des pores (5 µm) du filtre central des masques non tissés (schéma de droite).
https://www.nature.com/articles/s41598-022-15409-x

2 Kansas 50 à 80% de mortalité covid en plus dans les comtés où le port du masque était obligatoire
Une analyse de parallélisation basée sur les données au niveau des comtés a montré qu’au Kansas, les comtés avec mandat de masque avaient des taux de mortalité significativement plus élevés que les comtés sans mandat de masque, avec un rapport de risque de 1,85 (intervalle de confiance à 95 % [IC à 95 %] : 1,51-2,10). ) pour les décès liés au COVID-19. Même après ajustement pour le nombre de « personnes protégées », c’est-à-dire le nombre de personnes qui n’étaient pas infectées dans le groupe avec masque obligatoire par rapport au groupe sans masque, le rapport de risque est resté significativement élevé à 1,52 (IC à 95 % : 1,24-1,72). En analysant la surmortalité au Kansas, cette étude détermine que plus de 95 % de cet effet peut uniquement être attribué au COVID-19.
Ces résultats suggèrent que l’utilisation du masque pourrait constituer une menace encore inconnue pour l’utilisateur au lieu de le protéger, ce qui fait de l’obligation du masque une intervention épidémiologique discutable.
La cause de cette tendance est expliquée ici à l’aide de la théorie de « l’effet Foegen » ; c’est-à-dire que la réinhalation profonde de gouttelettes hypercondensées ou de virions purs capturés dans les masques faciaux sous forme de gouttelettes peut aggraver le pronostic et pourrait être liée aux effets à long terme de l’infection au COVID-19. Bien que « l’effet Foegen » soit prouvé in vivo sur un modèle animal, des recherches supplémentaires sont nécessaires pour le comprendre pleinement.
3 / L’ETUDE DE CAMBRIDGE
« Nous avons constaté que l’incidence des cas de COVID-19 autodéclarés était 33 % plus élevée chez ceux qui portaient souvent ou parfois des masques faciaux, et 40 % plus élevée chez ceux qui portaient des masques faciaux presque toujours ou toujours, par rapport aux participants qui ont déclaré ne jamais porter de masques faciaux. presque jamais. »
Les estimations brutes montrent une incidence plus élevée de tests positifs pour le COVID-19 dans les groupes qui utilisaient plus fréquemment des masques faciaux, avec 8,6 % des participants qui n’ont jamais ou presque jamais utilisé de masques, 15,0 % de participants qui utilisaient parfois des masques et 15,1 % des participants. les participants qui utilisaient presque toujours ou toujours des masques rapportant un résultat de test positif. Le risque était 1,74 (1,38 à 2,18) fois plus élevé chez ceux qui portaient souvent ou parfois des masques faciaux et 1,75 (1,39 à 2,21) fois plus élevé chez ceux qui portaient des masques faciaux presque toujours ou toujours, par rapport aux participants qui ont déclaré ne jamais ou presque jamais porter de masques faciaux. masques .

Nid à bactéries ? Ben oui…
J’aimeAimé par 1 personne
Ce qui compte en premier lieu chez un homme c’est son immunité et tout ce qui peut l’affaiblir en mauvais en soi !
C’est un principe fondamental de la physiologie animale.
J’aimeAimé par 1 personne
On a bien vu que le confinement était pire que le mal : il engendre des maladies auto-immunes par dépression du sujet humain !
Le confinement c’est réservé à des situations extrême quand il y a péril en la demeure en urgence absolu !
Pas pour une épidémie virale respiratoire. Erreur à ne surtout pas renouveler !
J’aimeJ’aime
C’est incroyable que le corps médical occidental – sous influence il faut le dire des labos et de l’OMS – fasse des erreurs de physiologie aussi capitales pour l’avenir du genre humain !
Le système immunitaire est central ce n’est pas anecdotique. Touchez à l’immunité c’est un crime collectif…
J’aimeAimé par 1 personne
Rien à voir avec la science ou la médecine, seulement pour
l’appât du gain, oui!
ce qui est difficile à comprendre, c’est la passivité, ou indifférence, d’une grande partie du corps médical et scientifique, et de la corruption admise!
J’aimeJ’aime
La « passivité » des scientifiques ?
Pour quelques-uns, sans doute. Mais ceux qui essaient de s’exprimer sont rendus inaudibles ou discrédités, là est le vrai problème.
Quant aux « médecins » et autres « soignants »; là c’est une autre paire de manches. La grande majorité est maintenue sous perfusion financière par les labos pharmaceutiques depuis plusieurs décennies. La doxa est donc bien installée.
En résumé ils hurlent avec les loups et ne vont pas mordre la main qui les nourrit, à l’image de la blonde K. L.
A-t-elle encore le temps de se recycler quand on regarde le calendrier de ses occupation extérieures avec les labos sur Transparence Santé.
J’aimeJ’aime
Ping: Les masques sont pires qu’inutiles / DES POUPONNIERES POUR LES BACTERIES ,LES CHAMPIGNONS et 50% de mortalité en plus pour les virus | Bretagne | Annuaire culturel
Ben quoi ? le masque créée un compost certes ; mais compost privé, personnel à soi même tout seul.
et puis une capote faciale, la journée, quand on pourchasse les infections respiratoires c’est logique depuis le départ.. La bébête qui sautait à 99 cms (ben oui, d’où les 1 mètre de distance) devait donc de préférence rester collée au slip de tronche parce que l’asymptomatisme à 14 jours près rodait partout..
et puis le COCO était tellement terrible avec son prolongement long, qu’au fond une bactérie c’est un moindre mal non ?
si en plus un COCO sous masque recréée un RECOCO masqué ultérieur, mais qui n’est pas un COCO long, ce n’est pas la même chose. Il vaut mieux deux COCOS courts qu’un long..non ?
Le bilan du masque n’est peut être pas positif mais il apporte un moins par rapport au plus..
J’aimeJ’aime
J’aimeAimé par 1 personne
si votre masque est un slip en coton pas trop bien lavé, c’est très sain. On peu vraiment parler de compost. Pas si c’est en fibre synthétiques qui ne se dégradent pas dans les poumons et qui sont sont des nids à champignons et bactéries.
J’aimeAimé par 1 personne
Pire qu’inutile ! Ça ne voudrait pas dire , nocif ?
Par le plus pur des hasards, en français bien de chez nous !
Décidément les études à la KON ui ne servent à rien, ça a l’iar d’occuper en ce moment. Z’ont rien d’autre à foutre cette bande de cloportes de faux scientifiques ?
J’aimeJ’aime
Oui, c’est un article qui souligne des évidences physiques, le masque n’est efficace qu’après désinfection, le temps de se saturer en pathogènes qui vont adorer ce milieu chaud, humide, ventilé et nutritif puisque près de la bouche donc il devient rapidement une barrière nocive.
Dans l’air, les pathogènes n’obéissent pas vraiment à la gravité du fait due la forte vitesse des molécules qui est de 500 m/s en moyenne mais sont retirés par les forces dipolaires et détruits par les UV. Franchement, nos politiques manquent de connaissances des lois de la nature et sont imbus d’eux mêmes de se planter à ce point sur des lois basiques de la physique. Qu’ils apprennent en observant le Gecko :
https://culturesciences.chimie.ens.fr/thematiques/chimie-du-vivant/les-forces-de-van-der-waals-et-le-gecko
J’aimeJ’aime
Et KillBill, à gesticulation corporelle paradoxale :
1
revoyez la vid avec volume sonore = 0 ; puis, analysez le pantomime de ses seules mains ! Vous comprendrez tout de son évanescence manipulatoire.
2
Puis, n’écoutez que la bande son – sans les images : vous découvrez un autre personnage tout aussi paradoxal, mais autrement.
3
Enfin, faites transcrire son message oral – verbal- par écrit, puis étudiez-en la syntaxe : elle est pis que paradoxale, elle se contredit, elle souffre de ne pouvoir soutenir une absence totale d’argument rationnel avéré. Juste signifier : je rêve, je veux, j’exige, j’ordonne !
4
Conclusion : KillBill est l’un des pire bonimenteurs et mystificateurs que la Terre ait porté, dont le songe éveillé récurrent, perpétuel procède d’une furieuse pathologie : posséder le Monde et le détruire (complexe d’emprise, ici extrêmement dangereux pour qui en résonnerait).
J’aimeAimé par 1 personne
Ping: La Science lui a donné raison mais l’Education nationale le persécute | Bretagne | Annuaire culturel
Finalement, les chirurgiens sont les rois des imbéciles puisqu’ils continuent à porter des masques malgré les études anti-masques ! Personnellement entre un « vaccin » à ARN baladeur qui n’est pas un vaccin et un masque, je porterai le masque ce qui me donnera l’impression (illusion peut-être) que je protège les autres. Quand ON fabriquera des vaccins suivant la technique Pasteur (Louis) je recommencerai à me faire vacciner.
J’aimeJ’aime